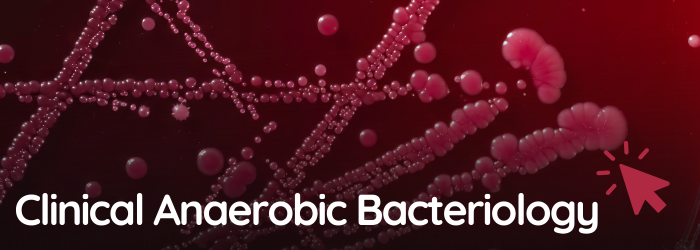
Clinical Bacteriology Webinar Series

Why Are Anaerobic Diagnostics Gaining Renewed Attention?
Anaerobic bacteria are no longer operating at the fringes of clinical microbiology. In recent years, they have re-emerged as significant pathogens, driven by increasingly complex infections, rising antimicrobial resistance (AMR), and advances in diagnostic technologies that now allow laboratories to detect them more routinely.
Clinical Importance
Obligate anaerobes are recognised contributors to serious infections including Clostridioides difficile infections (CDI), brain abscesses, diabetic foot ulcers, and oral diseases. At the same time, resistance to commonly prescribed antibiotics such as carbapenems and clindamycin is growing, making accurate identification and susceptibility testing more important than ever.
To support harmonised antimicrobial testing across Europe, the European Committee on Antimicrobial Susceptibility Testing (EUCAST) continues to refine guidance for anaerobic organisms.
Dr Sarah Copsey-Mawer, Senior Biomedical Scientist at the UK Anaerobe Reference Unit (UK ARU) in Cardiff recently shared updates during our Clinical Anaerobic Bacteriology webinar series. Dr Copsey-Mawer has overseen the implementation of EUCAST disc diffusion AST for anaerobes across Wales and is closely involved in ongoing developments to expand guidance.
Reflecting on changing resistance patterns, she noted that “not all anaerobes are susceptible to metronidazole anymore. That myth has gone out of the window.”
Watch the EUCAST AST of Anaerobes Identification and Significance Webinar
Technological Advancements & Training
Anaerobic infections are frequently polymicrobial and associated with high mortality, in part because their identification requires specialist expertise. Anaerobes also demand strictly controlled growth conditions, making isolation and testing particularly challenging.
This reinforces the need not only for the right equipment - with anaerobic workstations a go-to choice for many laboratories - but also for appropriate training and experience. As Dr Copsey-Mawer highlighted, even routine susceptibility testing can be compromised: “with metronidazole you can get false resistance if your anaerobic conditions aren’t correct.” This underscores the importance of precise control over oxygen levels, temperature, and humidity, conditions that can be reliably achieved using dedicated anaerobic workstations.
For this very reason Don Whitley Scientific (DWS) work with the UK ARU to run the annual Practical & Clinical Microbiology of Anaerobes Course (P&CMAn). This 2-day residential programme is delivered by the UK Anaerobe Reference Unit, Public Health Wales, Cardiff. A perfect blend of theory and practical, the P&CMAn Course is one of the UK's only, and longest running, anaerobic courses. The course aims to build understanding of anaerobic bacteria in clinical material, highlight their importance in clinical microbiology, develop basic competence in isolation and identification methods, and ultimately improve standards of anaerobic microbiology in clinical laboratories.
A Growing Focus on Education
The renewed focus on anaerobes extends beyond the UK. Dr Linda Veloo, University Medical Centre Groningen, highlights the scale of the challenge:
“Anaerobes in clinical setting deserve more attention due to their increasing antibiotic resistance, including resistance to last resort antibiotics. More than 95% of our commensal microbiome are anaerobes and sharing of antibiotic resistance genes between bacteria occurs as easily as children sharing chewing gum. “
Dr Veloo is also involved in delivering a Dutch training course similar to P&CMAn in Groningen, with the next event scheduled for 2027.
Dr Veloo and Dr Copsey-Mawer have recently collaborated on the upcoming fourth edition of Introduction to Clinical Anaerobic Bacteriology, published by Don Whitley Scientific and due for release this summer - further supporting laboratories with practical guidance as anaerobic diagnostics continue to evolve.
Together, advances in methodology, improved laboratory environments, and renewed emphasis on training are reshaping how anaerobic infections are diagnosed and managed. What was once considered niche is rapidly becoming central to modern clinical microbiology.
Watch our Clinical Anaerobic Bacteriology webinar series to learn more about recent developments and practical approaches to anaerobe identification.
au
England